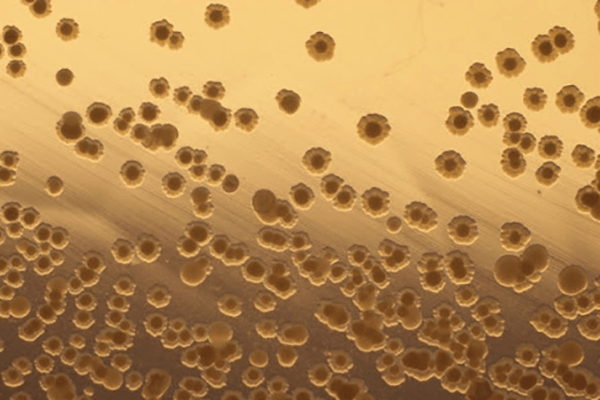

ОЧИСТКА И ДЕЗОДОРАЦИЯ ВОЗДУХА НА ПРЕДПРИЯТИИ
АБХУ - скруббер мокрой очистки газовых выбросов
Предлагаем Вам выбрать АБХУ – проверенное временем газоочистное оборудование для гарантированного решения задачи по снижению выбросов ЛОС (летучих органических соединений) до нормативных параметров ПДВ

Абсорбционно-биохимические установки (АБХУ) — это современные газоочистные системы, сочетающие преимущества мокрой очистки воздуха в абсорбере с последующей биохимической нейтрализацией загрязнителей в биореакторе, что исключает образование стока. Такие газоочистные аппараты особенно эффективны при очистке воздуха со сложным многокомпонентным составом от вредных выбросов, включая летучие органические соединения (ЛОС), некоторые неорганические соединения, взвешенные и смолистые вещества, а также неприятные запахи.
Мокрая газоочистка в таких системах обеспечивает улавливание ЛОС из воздуха, а биохимический этап — их разложение микроорганизмами до безвредных компонентов. Это делает технологию экологически безопасной и экономически выгодной в долгосрочной перспективе.
Мокрый скруббер (абсорбер) для очистки воздуха - это гарантированное решение задачи очистки воздуха на предприятии, снижения уровня выбросов ЛОС, сопутствующих веществ и удержания их в пределах нормативно допустимых параметров ПДВ.
Мокрая газоочистка в АБХУ на предприятиях от:
- фенола,
- формальдегида,
- аминов (триэтиламин, диметилэтиламин),
- бензола, этилбензола,
- метанола, бутанола,
- этилацетата, бутилацетата,
- фурфурола,
- ацетальдегида,
- уайт-спирита,
- ксилола, толуола,
- аммиака,
- и других летучих органических и некоторых неорганических соединений,
- сопутствующих взвешенных и смолистых веществ.
Эффективность абсорбционно-биохимических установок:
- Эффективность улавливания ЛОС до 96%
- Эффективность улавливания взвешенных веществ до 99%
Готовы работать с нестандартными задачами, разрабатывать индивидуальные решения
Технические характеристики АБХУ
| Показатель | Технические характеристики |
| Производительность по вентвоздуху | 5 000 / 10 000 / 15 000 / 20 000 / 25 000 / 30 000 / 50 000 м3/час |
| Энергозатраты на очистку 1000 м3 вентвоздуха | - мощность вентилятора и насоса 1,2 – 2,0 кВт - расход сжатого воздуха 0,5 – 1 нм3/ч |
| Расходные материалы | - вредные вещества, поступающие с вентвоздухом - вода технического качества для компенсации влагоуноса 0,1 – 1,5 м3/сут. - биогенные добавки (минеральные соли) 20-40 кг/год |
| Исполнение | из углеродистой стали с защитно-декоративным покрытием или из нержавеющей стали AISI 304. |
| Периодичность ремонта | Отсутствуют составные части с интенсивным износом. Периодическому обслуживанию подлежат вентилятор и водяной насос. |
| Обслуживание | Не требуется наличие постоянного оператора или высококвалифицированного персонала |
| Пуско-наладка | Специалисты ООО «Газоочистка инжиниринг» контролируют процесс монтажа оборудования и выезжают на объект для ввода АБХУ в эксплуатацию. Бесплатный авторский надзор в течение всего срока эксплуатации оборудования. |
Как работает АБХУ?
Очистка вентвоздуха в АБХУ основана на естественных природных процессах:
- первый заключается в том, что большинство вредных летучих органических соединений хорошо растворимы в технической воде;
- второй принцип основан на способности специально селекционированных и адаптированных микроорганизмов использовать в качестве источников питания растворенные в воде органические и некоторые неорганические вещества. В процессе потребления микроорганизмами этих соединений происходит их полная минерализация с образованием воды и углекислого газа.
В скруббере с подвижной шаровой насадкой при помощи водного абсорбента происходит улавливание вредных веществ, а в биореакторе – их нейтрализация. Микроорганизмы вводятся в биореактор один раз перед началом эксплуатации установки в виде концентрированной биомассы. Циркуляция раствора по замкнутому кругу «скруббер-биореактор» предотвращает образование производственного стока.

Принципиальная схема абсорбционно-биохимической установки:
1 – скруббер с массообменными решетками и шаровой насадкой; 2 – насос; 3 – биореактор с волокнистой насадкой и аэраторами; 4 – вентилятор; А и В – вход и выход вентвоздуха; С – абсорбционный раствор.
Компоненты АБХУ
Скруббер
Используется мокрая система очистки. Летучие органические соединения (ЛОС) растворяются или конденсируются в абсорбенте (вода технического качества), сопутствующие взвешенные и смолистые вещества улавливаются, не снижая эффективности работы газоочистного аппарата.
Подвижная шаровая насадка
Обеспечивает долговременный высокоинтенсивный массообмен между газовой и жидкой фазами. «Кипение» не позволяет смолистым и взвешенным веществам «забивать» слой насадки скруббера.
Биореактор
Биорегенерация водного абсорбента осуществляется с помощью дружественных человеку микроорганизмов-деструкторов для последующего многократного использования очищенной воды в замкнутом контуре установки – сток в канализацию отсутствует.
Каплеуловитель
Очищенный воздух перед попаданием в атмосферу проходит через каплеуловитель, что защищает вентиляционное оборудование, предотвращает каплеунос. Вода возвращается в биореактор АБХУ.
Шламоудаление
АБХУ оснащены устройством вывода шлама и конденсационных веществ.
АСУ ТП
Автоматизация эксплуатации АБХУ - дистанционный контроль параметров работы установок.
Эксплуатируемые АБХУ могут быть адаптированы к новым технологическим процессам.
Микроорганизмы
Микроорганизмы-деструкторы (МД) вводятся в биореактор один раз перед началом эксплуатации установки в виде концентрированной биомассы.
- Выделены из природных источников
- Не содержат искусственных модификаций геномов
- Нетоксичны и непатогенны (токсикологическая экспертиза Министерства здравоохранения Республики Беларусь)
- Нейтрализуют растворенные вредные органические вещества
>500
Концентрация микроорганизмов в водном абсорбенте саморегулируется в зависимости от количества поступающих вредных веществ.
Микробиологический анализ водных абсорбентов действующих установок показывает в среднем количество МД 104 клеток на 1 мл раствора. При остановке эксплуатации АБХУ по причине простоя технологического оборудования жизнедеятельность МД сохраняется многие месяцы.


Этапы работы
КОМПЛЕКСНОЕ РЕШЕНИЕ ЗАДАЧИ ПРОМЫШЛЕННОЙ ОЧИСТКИ ВЕНТВОЗДУХА ОТ ЛОС
- Позвоните нам по тел. +375 17 378 12 12 или напишите письмо в произвольной форме на info@abhu.ru.
Нам будет проще начать работу, если Вы пришлете заполненный опросный лист. - Консультирование по вопросу промышленной очистки воздуха от ЛОС на Вашем предприятии.
- Анализ выбросов от источника и разработка технологии очистки.
- Разработка планировочного решения исходя из требований и ограничений заказчика:
- компактное или распределенное исполнение,
- наружное (комбинированное) или внутреннее размещение.
5. Проектирование, производство и поставка оборудования:
- исполнение из нержавеющей стали
- исполнение из углеродистой стали с защитным декоративным покрытием.
6. Авторский надзор за вводом газоочистных установок в эксплуатацию.
7. Техническое обслуживание и профилактический предупредительный ремонт АБХУ (по запросу предприятия).
8. Сопровождение и технические консультации в течение всего срока службы.
Консультация специалиста
АБХУ очищает вентиляционный воздух до нормативов ПДВ
ГАРАНТИРОВАННОЕ РЕШЕНИЕ ПРОБЛЕМЫ ВЫБРОСОВ
В основе – многолетняя научно-исследовательская работа и мониторинг эксплуатации АБХУ на предприятиях
Экономичная
низкие эксплуатационные расходы и минимальное техническое обслуживание
Функциональная
ЭКОЛОГИЧНАЯ
Эффективная
Безопасная
отсутствие химических реагентов, кислот и щелочей. Пожарная безопасность
Необходимы рекомендации и коммерческое предложение?
Для выдачи рекомендаций по выбору оборудования для очистки промышленных газов и составления технико-коммерческого предложения заполните опросный лист и пришлите его нам через форму обратной связи или на электронную почту.